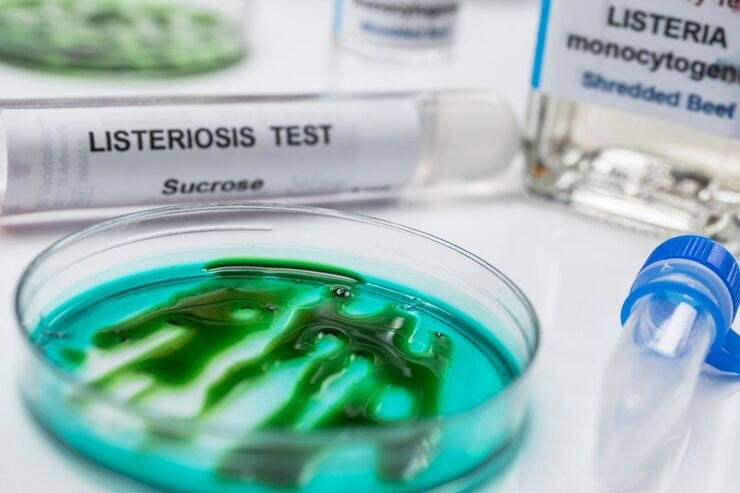

Latticini ritirati dal mercato per pericolo Listeria: ecco di quali si tratta e cosa fare se li hai in casa.
Cresce l’attenzione su ciò che portiamo in tavola e, in particolare, sui prodotti lattiero-caseari, tra gli alimenti più amati da adulti e bambini. In queste ore è stata segnalata una nuova allerta sanitaria che riguarda alcuni latticini: le autorità invitano chi ha effettuato acquisti recenti a verificare subito i prodotti presenti in frigorifero e in dispensa. L’indicazione, in caso di dubbio, è di sospendere il consumo e attenersi alle istruzioni ufficiali di richiamo. Prima di entrare nel merito del provvedimento, vale la pena chiarire di che tipo di rischio si parla e perché è importante non sottovalutarlo.

La Listeria monocytogenes è un batterio responsabile della listeriosi, un’infezione alimentare che può manifestarsi con sintomi variabili: febbre, disturbi gastrointestinali, dolori muscolari e, nei casi più gravi, complicanze come meningite o sepsi. L’aspetto peculiare di questo microrganismo è la capacità di sopravvivere e persino moltiplicarsi a basse temperature: non basta quindi il freddo del frigorifero a bloccarlo. La cottura accurata degli alimenti rappresenta invece un’arma efficace, perché il calore elevato inattiva il batterio.
La listeriosi è relativamente rara, ma i suoi esiti possono essere seri nelle persone più vulnerabili. Le categorie considerate a rischio comprendono donne in gravidanza, neonati e bambini molto piccoli, anziani, persone immunocompromesse o con patologie croniche.
Latticini ritirati dal mercato per pericolo Listeria
Per le fasce di popolazione più fragili, i servizi sanitari raccomandano particolare prudenza con i cibi pronti al consumo e con i prodotti a base di latte crudo. È sempre buona norma mantenere il frigorifero a una temperatura di 0-4 °C e pulirlo regolarmente, rispettare le date di scadenza e le modalità di conservazione indicate in etichetta, evitare contaminazioni crociate tra alimenti crudi e cotti, usando utensili e taglieri separati, riscaldare adeguatamente i piatti pronti prima del consumo, e per i soggetti a rischio, limitare o evitare formaggi a latte crudo e prodotti non pastorizzati.
In presenza di un avviso di richiamo legato a Listeria, la regola è semplice: non assaggiare il prodotto “per provare” e non consumarlo in alcun modo. Se lo si possiede in casa, occorre seguire le indicazioni riportate nell’avviso ufficiale, che prevedono la restituzione al punto vendita o, se non possibile, l’eliminazione in sicurezza. Dopo aver maneggiato un alimento potenzialmente contaminato, è opportuno lavare accuratamente le mani, le superfici e i contenitori venuti a contatto.
In particolare il Ministero della Salute ha diffuso il richiamo da parte del produttore di due lotti di formaggella a latte crudo del Caseificio Social Valsabbino. Il motivo indicato sull’avviso di richiamo è la presenza di Listeria monocytogenes in uno dei due lotti (l’altro è stato richiamato in via precauzionale). Il prodotto in questione è venduto in forme intere da 1,7 kg con i numeri di lotto 1445 e 1462. Non sono indicati termini minimi di conservazione o scadenze.
Il Caseificio Sociale Valsabbino Società Agricola Cooperativa ha prodotto i due lotti di formaggella richiamati. Lo stabilimento di produzione si trova in Località Mondalino, a Sabbio Chiese, in provincia di Brescia (marchio di identificazione IT 03 423 CE). A scopo precauzionale, l’azienda raccomanda di non consumare la formaggella a latte crudo con i numeri di lotto sopra indicati. Le consumatrici e i consumatori eventualmente in possesso del prodotto richiamato possono quindi restituirlo al punto vendita d’acquisto.





